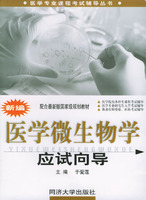

出版時間:2005-7-1
版 次:1
頁 數:305
字 數:395000
印刷時間:2005-7-1
開 本:
紙 張:膠版紙
印 次:
I S B N:9787560830407
包 裝:平裝
內容簡介
本書以《醫學微生物學》最新教材為基礎,緊扣教學大綱,並吸收教學第一線教師多年的教學經驗,同時參考了兄弟院校自編、協編有的關教材而編就的。它的特點是:著力挖掘知識的重點,解讀難點,梳理知識體系,涵蓋了《醫學微生物學》“三基”要求的全部內容和應掌握的英語辭彙;文字精練,概念清晰習題的難度有深有淺,適應不同層次讀者的需要。
本書各章的內容由教材精要、重點提示、測試題和參考答案等幾部分組成。教材精要中扼要提出本章的內容,便於了解內容概況。在重點提示中指出了學生所應掌握、熟悉和了解的主要內容。考生通過各章測試題的練習,可在較短的時間內掌握《醫生微生物學》的基本理論知識和各章重點、難點內容。為幫助學生了解和體會《醫學微生物學》考試的命題形式、方法和內容,書後提供了兩套模擬試題。學生在全面複習總結的基礎上,進行自我測試,以便了解複習的效果及體驗命題的規律和特點。
本書的讀者對象為醫學院校本科學生、專升本學生、報考研究生人員及參加應試的執業醫師等。
目錄
前言
答題說明
第一篇 微生物學的基本原理
第一章 緒論
第二章 微生物的生物學形狀
第三、四章 感染與抗感染免疫
第五章 遺傳與變異
第六章 醫學微生態學與醫院內感染
第七章 消毒與滅菌
第八章 病原學診斷與防治
第九章 細菌的耐藥性與控制
第二篇 細菌學
第十章 化膿性細菌
第十一章 腸道感染細菌
第十二章 厭氧性細菌
第十三章 呼吸道感染細菌
第十四章 動物源性細菌
第十五章 放線菌與諾卡菌
第十六章 螺旋體
第十七章 支原體和脲原體
第十八章 立克次體
第十九章 衣原體
第三篇 病毒學
第二十章 呼吸道感染病毒
第二十一章 腸道感染病毒
第二十二章 肝炎病毒
第二十三章 蟲媒病毒和出血熱病毒
第二十四章 人類皰疹病毒
第二十五章 反轉錄病毒
第二十六、二十七章 其他病毒與朊粒
第四篇 真菌學
第二十八、二十九章 主要病原性真菌
附錄一 教材輔導模擬試題(A)
附錄二 教材輔導模擬試題(B)
